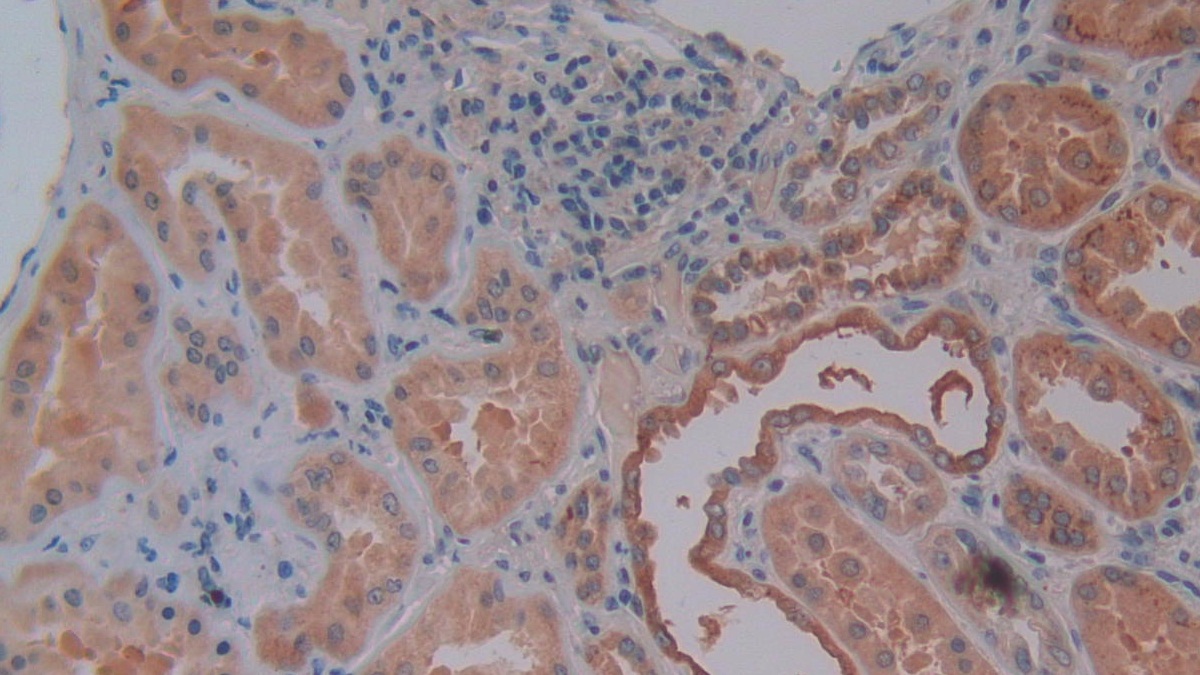
https://d1vffmuvmgkypt.cloudfront.net/image/ridacom_ltd/cloud_clone_corp/PRODUCT_SOURCE__CLOUD_CLONE__SUPPLIER__RIDACOM__ID__PAA899Si01__2

Antigen
SPP1
Isotype
IgG
(4)
IgG1
(1)
Reactivity
Human
(12)
Rat
(9)
Mouse
(8)
Dog
(3)
Simian
(3)
Cattle
(1)
Pig
(1)
Rabbit
(1)
Wild boar
(1)
Preparation method
Escherichia coli
(5)
293F
(4)
Research area
Bone metabolism
(18)
Tumor immunity
(18)
Clonality
Polyclonal
(11)
Monoclonal
(1)
Application
Sort
Western Blotting
(20)
Immunohistochemistry
(11)
Immunocytochemistry
(9)
Immunoprecipitation
(7)
Positive Control
(7)
SDS-PAGE
(7)
ELISA
(5)
Enzyme-linked immunosorbent assay for Antigen Detection
(5)
Cell Culture
(2)
Chemiluminescent immunoassay for antigen detection
(2)
IHC-P
(2)
Supplier
Cloud-Clone Corp.
(25)
Abbkine Scientific Co., Ltd.
(9)
Affinity Biosciences
(3)
Test method
Colorimetric
(7)
Double-antibody Sandwich
(7)
Host
Rabbit
(11)
CHO
(2)
Mouse
(1)
Category
Antibodies
(14)
ELISA Kits
(14)
Cell biology
(9)
Immunochemicals
(9)
Protein Biochemistry
(9)
Active Osteopontin (OPN)
$352.00

Antigen:
Osteopontin
Synonyms: SPP1; BNSP; BSPI; ETA1; Secreted Phosphoprotein 1; Bone Sialoprotein I; Early T-Lymphocyte Activation 1; Nephropontin; Urinary stone protein; Uropontin
Reactivity:Rat
Application:Cell Culture
Research area:Tumor immunity; Bone metabolism
Preparation method:293F
| 10µg | $352.00 | |
| 50µg | $880.00 | |
| 200µg | $1,760.00 |
| 1mg | $5,280.00 | |
| 5mg | $13,200.00 |
| 48T | $605.00 | |
| 96T | $864.00 | |
| 96T*5 | $3,888.00 |
| 96T*10 | $7,344.00 | |
| 96T*100 | $60,480.00 |
| 48T | $588.00 | |
| 96T | $840.00 | |
| 96T*5 | $3,780.00 |
| 96T*10 | $7,140.00 | |
| 96T*100 | $58,800.00 |
| 48T | $567.00 | |
| 96T | $810.00 | |
| 96T*5 | $3,645.00 |
| 96T*10 | $6,885.00 | |
| 96T*100 | $56,700.00 |
Active Osteopontin (OPN)
$94.00

Antigen:
Osteopontin
Synonyms: SPP1; BNSP; BSPI; ETA1; Secreted Phosphoprotein 1; Bone Sialoprotein I; Early T-Lymphocyte Activation 1; Nephropontin; Urinary stone protein; Uropontin
Reactivity:Human
Application:Cell Culture
Research area:Tumor immunity; Bone metabolism
Preparation method:Escherichia coli
| 10µg | $94.00 | |
| 50µg | $236.00 | |
| 200µg | $472.00 |
| 1mg | $1,416.00 | |
| 5mg | $3,540.00 |

Antigen:
Osteopontin
Synonyms: SPP1; BNSP; BSPI; ETA1; Secreted Phosphoprotein 1; Bone Sialoprotein I; Early T-Lymphocyte Activation 1; Nephropontin; Urinary stone protein; Uropontin
Reactivity:Human
Application:Positive Control; SDS-PAGE; Western Blotting
Research area:Tumor immunity; Bone metabolism
Preparation method:293F
| 10µg | $94.00 | |
| 50µg | $236.00 | |
| 200µg | $472.00 |
| 1mg | $1,416.00 | |
| 5mg | $3,540.00 |
Eukaryotic Osteopontin (OPN)
$300.00

Antigen:
Osteopontin
Synonyms: SPP1; BNSP; BSPI; ETA1; Secreted Phosphoprotein 1; Bone Sialoprotein I; Early T-Lymphocyte Activation 1; Nephropontin; Urinary stone protein; Uropontin
Reactivity:Rat
Application:Positive Control; SDS-PAGE; Western Blotting
Research area:Tumor immunity; Bone metabolism
Preparation method:293F
| 10µg | $300.00 | |
| 50µg | $750.00 | |
| 200µg | $1,500.00 |
| 1mg | $4,500.00 | |
| 5mg | $11,250.00 |
Eukaryotic Osteopontin (OPN)
$296.00

Antigen:
Osteopontin
Synonyms: SPP1; BNSP; BSPI; ETA1; Secreted Phosphoprotein 1; Bone Sialoprotein I; Early T-Lymphocyte Activation 1; Nephropontin; Urinary stone protein; Uropontin
Reactivity:Mouse
Application:Positive Control; SDS-PAGE; Western Blotting
Research area:Tumor immunity; Bone metabolism
Preparation method:293F
| 10µg | $296.00 | |
| 50µg | $740.00 | |
| 200µg | $1,480.00 |
| 1mg | $4,440.00 | |
| 5mg | $11,100.00 |
| 48T | $479.00 | |
| 96T | $684.00 | |
| 96T*5 | $3,078.00 |
| 96T*10 | $5,814.00 | |
| 96T*100 | $47,880.00 |
| 48T | $479.00 | |
| 96T | $684.00 | |
| 96T*5 | $3,078.00 |
| 96T*10 | $5,814.00 | |
| 96T*100 | $47,880.00 |

Antigen:
Osteopontin
Synonyms: SPP1; BNSP; BSPI; ETA1; Secreted Phosphoprotein 1; Bone Sialoprotein I; Early T-Lymphocyte Activation 1; Nephropontin; Urinary stone protein; Uropontin
Reactivity:Dog
Application:Positive Control; SDS-PAGE; Western Blotting
Research area:Tumor immunity; Bone metabolism
Preparation method:Escherichia coli
| 10µg | $200.00 | |
| 50µg | $500.00 | |
| 200µg | $1,000.00 |
| 1mg | $3,000.00 | |
| 5mg | $7,500.00 |
| 48T | $349.00 | |
| 96T | $498.00 | |
| 96T*5 | $2,241.00 |
| 96T*10 | $4,233.00 | |
| 96T*100 | $34,860.00 |

Antigen:
Osteopontin
Synonyms: SPP1; BNSP; BSPI; ETA1; Secreted Phosphoprotein 1; Bone Sialoprotein I; Early T-Lymphocyte Activation 1; Nephropontin; Urinary stone protein; Uropontin
Reactivity:Simian
Application:Positive Control; SDS-PAGE; Western Blotting
Research area:Tumor immunity; Bone metabolism
Preparation method:Escherichia coli
| 10µg | $184.00 | |
| 50µg | $460.00 | |
| 200µg | $920.00 |
| 1mg | $2,760.00 | |
| 5mg | $6,900.00 |
| 48T | $307.00 | |
| 96T | $438.00 | |
| 96T*5 | $1,971.00 |
| 96T*10 | $3,723.00 | |
| 96T*100 | $30,660.00 |

Antigen:
Osteopontin
Synonyms: SPP1; BNSP; BSPI; ETA1; Secreted Phosphoprotein 1; Bone Sialoprotein I; Early T-Lymphocyte Activation 1; Nephropontin; Urinary stone protein; Uropontin
Reactivity:Mouse
Application:Positive Control; SDS-PAGE; Western Blotting
Research area:Tumor immunity; Bone metabolism
Preparation method:Escherichia coli
| 10µg | $168.00 | |
| 50µg | $420.00 | |
| 200µg | $840.00 |
| 1mg | $2,520.00 | |
| 5mg | $6,300.00 |

Antigen:
Osteopontin
Synonyms: SPP1; BNSP; BSPI; ETA1; Secreted Phosphoprotein 1; Bone Sialoprotein I; Early T-Lymphocyte Activation 1; Nephropontin; Urinary stone protein; Uropontin
Reactivity:Human
Application:Positive Control; SDS-PAGE; Western Blotting
Research area:Tumor immunity; Bone metabolism
Preparation method:Escherichia coli
| 10µg | $92.00 | |
| 50µg | $230.00 | |
| 200µg | $460.00 |
| 1mg | $1,380.00 | |
| 5mg | $3,450.00 |

Antigen:
Osteopontin
Synonyms: SPP1; BNSP; BSPI; ETA1; Secreted Phosphoprotein 1; Bone Sialoprotein I; Early T-Lymphocyte Activation 1; Nephropontin; Urinary stone protein; Uropontin
Host:Rabbit
Reactivity:Simian
Application:Western Blotting; Immunohistochemistry; Immunocytochemistry; Immunoprecipitation
Clonality:Polyclonal
Research area:Tumor immunity; Bone metabolism
| 20µl | $121.00 | |
| 100µl | $283.00 | |
| 200µl | $404.00 |
| 1ml | $1,010.00 | |
| 10ml | $4,040.00 |
SPP1 Antibody
$280.00

Antigen:
Osteopontin
Synonyms: Bone sialoprotein 1; Nephropontin; Secreted phosphoprotein 1; Urinary stone protein; Uropontin; OSTP_HUMAN; B2RDA1; P10451; Q15681; Q15682; Q15683; Q4W597; Q567T5; Q8NBK2; Q96IZ1
Host:Rabbit
Reactivity:Human; Mouse; Rat
Application:Western Blotting; Immunohistochemistry; ELISA
Isotype:IgG
Clonality:Polyclonal
Aliases:BNSP; Bone sialoprotein 1; BSP I; BSPI; Early T lymphocyte activation 1; ETA 1; ETA1; MGC110940; Nephropontin; OPN; Osteopontin; osteopontin/immunoglobulin alpha 1 heavy chain constant region fusion protein; OSTP_HUMAN; PSEC0156; secreted phosphoprotein 1 (osteopontin, bone sialoprotein I, early T-lymphocyte activation 1); Secreted phosphoprotein 1; SPP 1; SPP-1; SPP1; SPP1/CALPHA1 fusion; Urinary stone protein; Uropontin
Osteopontin Antibody
$280.00

Antigen:
Osteopontin
Synonyms: Bone sialoprotein 1; Nephropontin; Secreted phosphoprotein 1; Urinary stone protein; Uropontin; OSTP_HUMAN; B2RDA1; P10451; Q15681; Q15682; Q15683; Q4W597; Q567T5; Q8NBK2; Q96IZ1
Host:Rabbit
Reactivity:Human; Mouse; Rat
Application:Western Blotting; ELISA
Isotype:IgG
Clonality:Polyclonal
Aliases:BNSP; Bone sialoprotein 1; BSP I; BSPI; Early T lymphocyte activation 1; ETA 1; ETA1; MGC110940; Nephropontin; OPN; Osteopontin; osteopontin/immunoglobulin alpha 1 heavy chain constant region fusion protein; OSTP_HUMAN; PSEC0156; secreted phosphoprotein 1 (osteopontin, bone sialoprotein I, early T-lymphocyte activation 1); Secreted phosphoprotein 1; SPP 1; SPP-1; SPP1; SPP1/CALPHA1 fusion; Urinary stone protein; Uropontin
| 100μl | $280.00 |
| 200μl | $350.00 |

Antigen:
Osteopontin
Synonyms: Bone sialoprotein 1; Secreted phosphoprotein 1; OSTP_PIG; P14287
Test method:Colorimetric
Osteopontin (OPN), is a secreted multifunctional glyco-phosphoprotein with roles in bone metabolism, immune regulation, tissue remodeling , cell survival, and tumor progression . Gene structure and chromosomal location identify OPN as a member of the small integrin-binding ligand N-linked glycoprotein (SIBLING) family that also includes BSP,BMP1,DSPP, ENAM and MEPE. Murine OPN issynthesized as a 294 amino acid (aa) precursor protein with a predicted 16 aa signal peptide and a highly unusual mature protein sequence, containing 68 acidic aa and 23 potential Ser/Thr phosphorylation sites. Although the predicted molecular weight of OPN is 31 kDa,phosphorylation and N- and O-glycosylation may allow it to appear as large as 75 kDa. Variability in post-translational modifications can influence the activity of OPN.
| 48T | $280.00 | |
| 96T | $480.00 |
| 96T*5 | $2,160.00 | |
| 96T*50 | $20,160.00 |

Antigen:
Osteopontin
Synonyms: Bone sialoprotein 1; OC-1; Secreted phosphoprotein 1; OSTP_RABIT; P31097; P46631
Test method:Colorimetric
Osteopontin (OPN), is a secreted multifunctional glyco-phosphoprotein with roles in bone metabolism, immune regulation, tissue remodeling , cell survival, and tumor progression . Gene structure and chromosomal location identify OPN as a member of the small integrin-binding ligand N-linked glycoprotein (SIBLING) family that also includes BSP,BMP1,DSPP, ENAM and MEPE. Murine OPN issynthesized as a 294 amino acid (aa) precursor protein with a predicted 16 aa signal peptide and a highly unusual mature protein sequence, containing 68 acidic aa and 23 potential Ser/Thr phosphorylation sites. Although the predicted molecular weight of OPN is 31 kDa,phosphorylation and N- and O-glycosylation may allow it to appear as large as 75 kDa. Variability in post-translational modifications can influence the activity of OPN.
| 48T | $280.00 | |
| 96T | $480.00 |
| 96T*5 | $2,160.00 | |
| 96T*50 | $20,160.00 |

Antigen:
Osteopontin
Synonyms: Bone sialoprotein 1; OC-1; Secreted phosphoprotein 1; OSTP_RABIT; P31097; P46631
Test method:Colorimetric
Osteopontin (OPN), is a secreted multifunctional glyco-phosphoprotein with roles in bone metabolism, immune regulation, tissue remodeling , cell survival, and tumor progression . Gene structure and chromosomal location identify OPN as a member of the small integrin-binding ligand N-linked glycoprotein (SIBLING) family that also includes BSP,BMP1,DSPP, ENAM and MEPE. Murine OPN issynthesized as a 294 amino acid (aa) precursor protein with a predicted 16 aa signal peptide and a highly unusual mature protein sequence, containing 68 acidic aa and 23 potential Ser/Thr phosphorylation sites. Although the predicted molecular weight of OPN is 31 kDa,phosphorylation and N- and O-glycosylation may allow it to appear as large as 75 kDa. Variability in post-translational modifications can influence the activity of OPN.
| 48T | $280.00 | |
| 96T | $480.00 |
| 96T*5 | $2,160.00 | |
| 96T*50 | $20,160.00 |

Antigen:
Osteopontin
Synonyms: Bone sialoprotein 1; Secreted phosphoprotein 1; OSTP_SHEEP; Q9XSY9
Test method:Colorimetric
Osteopontin (OPN), is a secreted multifunctional glyco-phosphoprotein with roles in bone metabolism, immune regulation, tissue remodeling , cell survival, and tumor progression . Gene structure and chromosomal location identify OPN as a member of the small integrin-binding ligand N-linked glycoprotein (SIBLING) family that also includes BSP,BMP1,DSPP, ENAM and MEPE. Murine OPN issynthesized as a 294 amino acid (aa) precursor protein with a predicted 16 aa signal peptide and a highly unusual mature protein sequence, containing 68 acidic aa and 23 potential Ser/Thr phosphorylation sites. Although the predicted molecular weight of OPN is 31 kDa,phosphorylation and N- and O-glycosylation may allow it to appear as large as 75 kDa. Variability in post-translational modifications can influence the activity of OPN.
| 48T | $280.00 | |
| 96T | $480.00 |
| 96T*5 | $2,160.00 | |
| 96T*50 | $20,160.00 |

Antigen:
Osteopontin
Synonyms: Bone sialoprotein 1; Secreted phosphoprotein 1; OSTP_CHICK; P23498
Test method:Colorimetric
Osteopontin (OPN), is a secreted multifunctional glyco-phosphoprotein with roles in bone metabolism, immune regulation, tissue remodeling , cell survival, and tumor progression . Gene structure and chromosomal location identify OPN as a member of the small integrin-binding ligand N-linked glycoprotein (SIBLING) family that also includes BSP,BMP1,DSPP, ENAM and MEPE. Murine OPN issynthesized as a 294 amino acid (aa) precursor protein with a predicted 16 aa signal peptide and a highly unusual mature protein sequence, containing 68 acidic aa and 23 potential Ser/Thr phosphorylation sites. Although the predicted molecular weight of OPN is 31 kDa,phosphorylation and N- and O-glycosylation may allow it to appear as large as 75 kDa. Variability in post-translational modifications can influence the activity of OPN.
| 48T | $280.00 | |
| 96T | $480.00 |
| 96T*5 | $2,160.00 | |
| 96T*50 | $20,160.00 |




-APA899Ra61-000001.png)



-SCA899Mu-000001.png)



-SCA899Hu-000001.png)



-SEA899Si-000001.png)



-APA899Hu61-000001.png)












-SEA899Ra-000001.png)



-E90899Rb-000001.png)






-SEA899Mu-000001.png)





-SEA899Hu-000001.png)


-RPA899Mu01-000001.png)


-RPA899Hu02-000001.png)